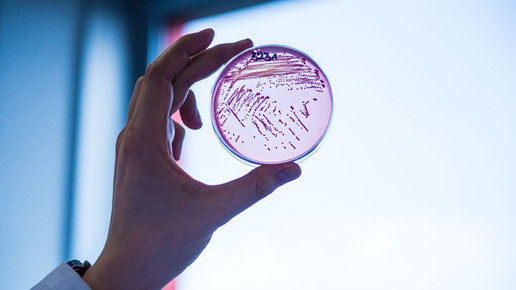

E. coli: Gefährlicher Stamm entdeckt
Gefährlicher Keim: Eigentlich ist der ohnehin im Darm lebende Bakterienstamm Escherichia coli harmlos. Nur einige Stämme können Infektionen auslösen, wenn sie sich außerhalb des Darms befinden. Eine Antibiose kann unerlässlich sein. Jetzt gibt es jedoch einen Problemkeim, der sich innerhalb von sieben Jahren rasant ausgebreitet hat und gegen mehrere Antibiotika resistent ist.
In Krankenhäusern sind multiresistente Keime (MRSA) seit Langem ein gefürchtetes Problem. Die resistenten Superkeime haben jetzt „Zuwachs“ bekommen: Wissenschaftler des Deutsches Zentrums für Infektionsforschung (DZIF) der Universität Gießen konnten nachweisen, dass sich der Stamm ST131 CTX-M27 rasant ausbreitet. War er im Jahr 2009 noch nicht nachweisbar, stieg die Häufigkeit im Jahr 2016 auf 45 Prozent an. Der multiresistente Keim wurde ausschließlich in menschlichen Isolaten identifiziert.
Der Stamm hat ein bestimmtes Enzym als Abwehrmechanismus entwickelt, das Antibiotika unwirksam macht. Diese sogenannten Beta-Lactamasen mit erweitertem Spektrum (ESBL) können den Erreger multiresistent machen. Der E. coli vom Sequenztyp 131 (ST131) ist weltweit für Millionen von Infektionen verantwortlich und verursacht vor allem Blutstrominfektionen und Blasenentzündungen. Der Erreger trägt das relativ seltene ESBL-Gen blaCTX-M-27.
Den neuen Superkeim identifizierten die Wissenschaftler aus fast 1000 Isolaten von ESBL-produzierenden Bakterien, die nicht nur den Menschen, sondern auch Tiere, Umwelt und Lebensmittel besiedeln. „Wir müssen besonders eine Untergruppe eines multiresistenten E. coli-Bakteriums im Blick behalten, die wir in unserer aktuellen Studie gefunden haben“, erklärt Professor Dr. Trinad Chakraborty, Direktor des Instituts für Medizinische Mikrobiologie an der JLU in Gießen und Koordinator am DZIF-Standort Gießen-Marburg-Langen. Gemeint ist die Untergruppe, die nun auch in Deutschland zu finden ist und aktuell weltweit auf dem Vormarsch ist.
„Damit macht dieser E. coli-Stamm mit seinem spezifischen ESBL-Gen einem E. coli ST131-Stamm Konkurrenz, der bisher in Deutschland am häufigsten nachgewiesen wurde und ein anderes ESBL-Gen trägt“, erklärt Dr. Can Imirzalioglu, Wissenschaftler der Uni Gießen. Die Ergebnisse wurden im Fachjournal „Emerging Infectious Diseases“ veröffentlicht.
E. coli zählt zu den gramnegativen Enterobakterien und besiedelt den menschlichen Darm. Befinden sich einige Stämme außerhalb des Darms, können sie vor allem bei geschwächten Patienten Infektionen auslösen, die im Falle einer Resistenz gefürchtet und schwer zu behandeln sind.
Die Wissenschaftler können erst nach weiteren Studien Genaueres über die Ursachen und die klinische Bedeutung des Keims sagen. Die Ergebnisse der Studie zeigen, wie essentiell Verfahren wie die Genomsequenzierung sind, um derartige Entwicklungen von Bakterien zu identifizieren um dagegen vorgehen zu können.

APOTHEKE ADHOC Debatte